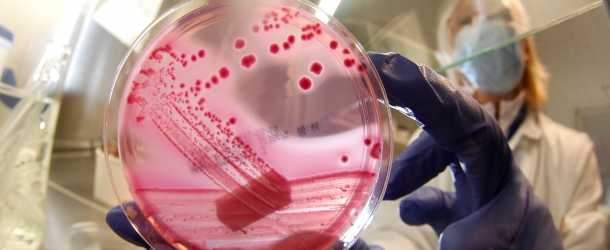

Spanyolországban két gyerek meghalt az ismeretlen eredetű májgyulladásban, amelynek megjelenését eddig 21 európai országból jelentették – közölte a spanyol egészségügyi minisztérium pénteken.
A gyermekek körében terjedő hepatitisz első két spanyol halálos áldozata egy 15 hónapos andalúziai és egy hatéves murciai kisgyerek. A gyulladás miatt mindkettőjükön májátültetést hajtottak végre, de életüket így sem sikerült megmenteni.
Spanyolországban április óta 46 ilyen megbetegedést jelentettek, amely több mint 60 százalékban lányokat érintett. Három páciens állapota fordult annyira súlyosra, hogy transzplantációt kellett végezni.
A szaktárca legutóbbi, július 17-én adott tájékoztatása óta kilenc új megbetegedést diagnosztizáltak. Az esetek közötti lehetséges járványos összefüggést a minisztérium kizárta. A májgyulladás jellemző tünetei: hányás, láz, hasfájás, de több esetben sárgaságról, hasmenésről, légúti problémákról és bőrkiütésekről is beszámoltak a szakemberek.
Európából július végéig 507, az amerikai kontinensről 487 esetet jelentettek – olvasható spanyol jelentésben. Egészségügyi Világszervezet (WHO) áprilisban hívta fel a figyelmet a gyerekeket érintő, ismeretlen eredetű heveny májgyulladás megjelentésére.